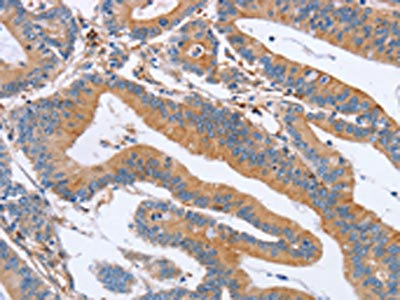

CDC7 Antibody
-
中文名稱:CDC7兔多克隆抗體
-
貨號:CSB-PA039310
-
規格:¥1100
-
圖片:
-
The image on the left is immunohistochemistry of paraffin-embedded Human liver cancer tissue using CSB-PA039310(CDC7 Antibody) at dilution 1/70, on the right is treated with synthetic peptide. (Original magnification: ×200)
-
The image on the left is immunohistochemistry of paraffin-embedded Human colon cancer tissue using CSB-PA039310(CDC7 Antibody) at dilution 1/70, on the right is treated with synthetic peptide. (Original magnification: ×200)
-
-
其他:
產品詳情
-
Uniprot No.:
-
基因名:
-
別名:Cdc 7 antibody; CDC7 antibody; CDC7 cell division cycle 7 antibody; CDC7 cell division cycle 7 like 1 antibody; Cdc7 Kinase antibody; CDC7 L1 antibody; Cdc7 like 1 antibody; CDC7 related kinase antibody; CDC7-related kinase antibody; CDC7_HUMAN antibody; CDC7L 1 antibody; CDC7L1 antibody; Cell division cycle 7 homolog antibody; Cell division cycle 7 kinase antibody; Cell division cycle 7 like protein 1 antibody; Cell division cycle 7 related protein kinase antibody; Cell division cycle 7-related protein kinase antibody; HsCDC 7 antibody; HsCdc7 antibody; Hsk 1 antibody; Hsk1 antibody; HuCDC 7 antibody; huCdc7 antibody; MGC117361 antibody; MGC126237 antibody; MGC126238 antibody
-
宿主:Rabbit
-
反應種屬:Human,Mouse
-
免疫原:Synthetic peptide of Human CDC7
-
免疫原種屬:Homo sapiens (Human)
-
標記方式:Non-conjugated
-
抗體亞型:IgG
-
純化方式:Antigen affinity purification
-
濃度:It differs from different batches. Please contact us to confirm it.
-
保存緩沖液:-20°C, pH7.4 PBS, 0.05% NaN3, 40% Glycerol
-
產品提供形式:Liquid
-
應用范圍:ELISA,IHC
-
推薦稀釋比:
Application Recommended Dilution ELISA 1:2000-1:10000 IHC 1:100-1:300 -
Protocols:
-
儲存條件:Upon receipt, store at -20°C or -80°C. Avoid repeated freeze.
-
貨期:Basically, we can dispatch the products out in 1-3 working days after receiving your orders. Delivery time maybe differs from different purchasing way or location, please kindly consult your local distributors for specific delivery time.
-
用途:For Research Use Only. Not for use in diagnostic or therapeutic procedures.
相關產品
靶點詳情
-
功能:Seems to phosphorylate critical substrates that regulate the G1/S phase transition and/or DNA replication. Can phosphorylate MCM2 and MCM3.
-
基因功能參考文獻:
- Higher expression of CDC7 in odontogenic keratocyst (OKC) and radicular cyst was shown in comparison to dentigerous cyst, while radicular cyst and OKC groups showed no difference in CDC7 expression. PMID: 30012245
- Results suggest a new role of Claspin in initiation of DNA replication during normal S phase through the recruitment of Cdc7 that facilitates phosphorylation of Mcm proteins. PMID: 27401717
- Increased Cdc7-dependent replication initiation is a hallmark of p53 gain-of function mutations in lung adenocarcinoma. PMID: 28887320
- Both CDC7 and DBF4 promoters bind E2F, suggesting that increased E2F activity in RB1 mutant cancers promotes increased DDK expression. Surprisingly, increased DDK expression levels are also correlated with both increased chemoresistance and genome-wide mutation frequencies. PMID: 28448802
- p53-dependent control of CDC7 levels is essential for blocking G1/S cell-cycle transition upon genotoxic stress. PMID: 27611229
- we propose that phosphorylation of TOP2A by CDC7/DBF4 in early S-phase prevents its localization and/or activity at centromeres, and inhibition of TOP2A function could be relevant to prevent premature separation of centromeric DNA. PMID: 27407105
- The data support a model where Cdc7 (de)phosphorylation is the molecular switch for the activation and inactivation of DNA replication in mitosis, directly connecting Cdc7 and PP1a/Cdk1 to the regulation of once-per-cell cycle DNA replication in mammalian cells. PMID: 27105124
- Our data show that Cdc7 is highly expressed in colorectal cancer PMID: 26208856
- The presence of the index SNP rs1192415 (TGFBR3-CDC7) was associated with visual field progression in POAG (primary open-angle glaucoma) patients. PMID: 26383992
- MiR-630 promoted apoptosis by downregulation of CDC7. PMID: 25255219
- The state of DUE-B phosphorylation is maintained by the equilibrium between Cdc7-dependent phosphorylation and PP2A-dependent dephosphorylation. PMID: 25258324
- The interaction between Claspin and Cdc7 is not dependent on Cdc7 kinase activity, but Claspin interaction with the DNA helicase subunit Mcm2 is lost upon Cdc7 inhibition. PMID: 23598722
- huCdc7 may play an important role in the development and progression of colorectal cancer. PMID: 23716994
- Cdcy is universally up-regulated in oral squamous cell carcinoma is an independent prognostic marker, contributing to resistance to DNA damaging agents. PMID: 23684929
- The results suggest that CDC7 expression level can be specific prognostic factors for Diffuse large B-cell lymphoma patients PMID: 22528513
- Significantly higher levels of apoptosis were detected in siCDC7-transfected cells. PMID: 22806309
- Cdc7 phosphorylates and interacts with Tob to inhibit the Cul4-DDB1(Cdt2)-dependent Tob degradation. PMID: 23066029
- cell death process induced by Cdc7 depletion PMID: 22574151
- bipartite interaction between Cdc7 and Dbf4/ASK subunits facilitates ATP binding and substrate recognition by the Cdc7 kinase. PMID: 21536671
- Inhibition of Cdc7 kinase activity in cancer cells restricts DNA replication and induces apoptotic cell death by an unprecedented molecular mechanism of action. PMID: 20647475
- Data syggest important implications for the continued development of promising Cdc7-targeted cancer therapies. PMID: 20707412
- cell division cycle 7 is a replication associated protein with relationships to gene amplification and genomic instability in breast carcinomas. PMID: 19896697
- Data show that CDC7L1 and CDC10 was up-regulated but the expression of CDK9, CDC20 and CLK3 was down- regulated in azoospermic testes. PMID: 19426592
- The interaction with LEDGF relieves autoinhibition of Cdc7-ASK kinase, imposed by the C terminus of ASK. PMID: 19864417
- Drf1, a nuclear cell cycle-regulated protein binds to Cdc7 and activates the kinase PMID: 12065429
- Down-regulation of Cdc7 by small interfering RNA in a variety of tumor cell lines causes an abortive S phase, leading to cell death by either p53-independent apoptosis or aberrant mitosis. PMID: 15466207
- CR (periphilin) retards S-phase progression by modifying expression of Cdc7 and other genes involved in progression of DNA replication PMID: 15474462
- ASKL1 in a complex with Cdc7 may play a role in normal progression of both S and M phases PMID: 15668232
- CINP is part of the Cdc7-dependent mechanism of origin firing and a functional and physical link between Cdk2 and Cdc7 complexes at the origins PMID: 16082200
- the majority of the Mcm2 isoforms phosphorylated by Cdc7 are not stably associated with chromatin PMID: 16446360
- Cdc7-Dbf4 kinase efficiently phosphorylates p150. PMID: 16826239
- Results describe the mapping of the sites in human Mcm2 protein that are phosphorylated by Cdc7. PMID: 16864800
- Taken together, these results indicate that Cdc7/Dbf4 phosphorylation of MCM2 is essential for the initiation of DNA replication in mammalian cells. PMID: 16899510
- MCM4 phosphorylation by Cdc7 kinase facilitates its interaction with Cdc45 on chromatin PMID: 17046832
- Cdc7 kinase plays a role in maintaining cell viability during replication stress PMID: 17062569
- Cdc7/Dbf4 kinase activity inhibition affects specific phosphorylation sites on MCM2 in cancer cells PMID: 18286467
- the ATR-dependent activation of the p38 MAP kinase is a major signaling pathway that induces apoptotic cell death after depletion of Cdc7 in cancer cells PMID: 18625709
- increased Cdc7-Dbf4 abundance may be a common occurrence in human malignancies PMID: 18714392
- chromatin-bound CDT1 is first stabilized and subsequently displaced by CDC7 activity, thereby ensuring the timely execution of DNA replication PMID: 19054765
- These results indicate that Ddk functions as an upstream regulator to monitor S-phase checkpoint signaling. PMID: 19111665
- differences in Cdc7 expression may account for some of the differences between malignant melanomas and benign melanocytic nevi. PMID: 19278428
- Increased Cdc7 protein levels were significantly associated with arrested tumor differentiation, advanced clinical stage, genomic instability, and accelerated cell cycle progression. PMID: 19318489
- Cdc7 phosphorylates Mcm2 promoting pre-replication complex assembly. PMID: 19647517
顯示更多
收起更多
-
亞細胞定位:Nucleus.
-
蛋白家族:Protein kinase superfamily, Ser/Thr protein kinase family, CDC7 subfamily
-
數據庫鏈接:
Most popular with customers
-
-
YWHAB Recombinant Monoclonal Antibody
Applications: ELISA, WB, IHC, IF, FC
Species Reactivity: Human, Mouse, Rat
-
-
-
-
-
-